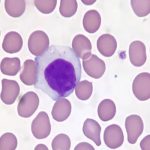

Descoberta revela obstáculo oculto no combate ao câncer; veja
Em muitos casos, pacientes que inicialmente respondem bem a determinados tratamentos contra o câncer passam, com o tempo, a não apresentar mais melhora. Esse fenômeno intriga médicos e pesquisadores, especialmente no campo da imunoterapia. Agora, um novo estudo ajuda a explicar por que o próprio sistema de defesa pode perder força diante dos tumores.
A pesquisa foi conduzida por cientistas da Universidade de Montreal, no Canadá, liderados por André Veillette, e publicada na revista científica Nature. Os pesquisadores identificaram o papel da molécula SLAMF6 (também chamada de Ly108), localizada na superfície das células T: glóbulos brancos fundamentais no combate a células cancerígenas. Essa molécula atua como um “freio” interno que reduz a capacidade de ataque dessas células.
O Papel da Molécula SLAMF6 na Imunoterapia
Segundo reportagem na Revista Galileu, o estudo mostrou que a SLAMF6 envia sinais diretos que enfraquecem as células T, diminuindo sua durabilidade e acelerando um processo chamado exaustão imunológica. Diferentemente de outros mecanismos, ela não precisa interagir diretamente com o tumor para comprometer a resposta antitumoral, o que torna sua atuação ainda mais relevante.
Atualmente, imunoterapias que utilizam inibidores de PD1 e PDL1 conseguem bloquear parte desses freios imunológicos. No entanto, muitos pacientes não respondem ou deixam de responder a esses tratamentos ao longo do tempo. Para contornar o problema, a equipe desenvolveu novos anticorpos monoclonais capazes de impedir a ação da SLAMF6. Em testes com camundongos, houve maior ativação das células T e respostas antitumorais mais robustas.
Próximos Passos e Implicações Clínicas
“Esses freios estimulam a parada das células imunológicas”, explica Veillette ao descrever como a molécula reduz a eficácia do sistema imune. Segundo o pesquisador, os novos anticorpos surgem como candidatos promissores para uma próxima geração de imunoterapias, podendo ser usados isoladamente ou combinados a outros tratamentos. A próxima etapa envolve ensaios clínicos iniciais para avaliar segurança e eficácia em pacientes com tumores sólidos e cânceres hematológicos.
Fonte: Diário do Pará e Publicado Por: Jornal Folha do Progresso em 14/02/2026/11:40:01
O formato de distribuição de notícias do Jornal Folha do Progresso pelo celular mudou. A partir de agora, as notícias chegarão diretamente pelo formato Comunidades, ou pelo canal uma das inovações lançadas pelo WhatsApp. Não é preciso ser assinante para receber o serviço. Assim, o internauta pode ter, na palma da mão, matérias verificadas e com credibilidade. Para passar a receber as notícias do Jornal Folha do Progresso, clique nos links abaixo siga nossas redes sociais:
Apenas os administradores do grupo poderão mandar mensagens e saber quem são os integrantes da comunidade. Dessa forma, evitamos qualquer tipo de interação indevida. Sugestão de pauta enviar no e-mail:folhadoprogresso.jornal@gmail.com.
Envie vídeos, fotos e sugestões de pauta para a redação do JFP (JORNAL FOLHA DO PROGRESSO) Telefones: WhatsApp (93) 98404 6835– (93) 98117 7649.
“Informação publicada é informação pública. Porém, para chegar até você, um grupo de pessoas trabalhou para isso. Seja ético. Copiou? Informe a fonte.”
Publicado por Jornal Folha do Progresso, Fone para contato 93 981177649 (Tim) WhatsApp:-93- 984046835 (Claro) -Site: www.folhadoprogresso.com.br e-mail:folhadoprogresso.jornal@gmail.com/ou e-mail: adeciopiran.blog@gmail.com